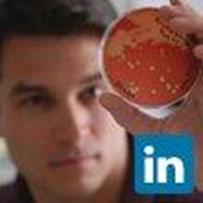
Profile picture

Chad W Euler
Doctorate
-
Hunter College (CUNY)New York City, United States
